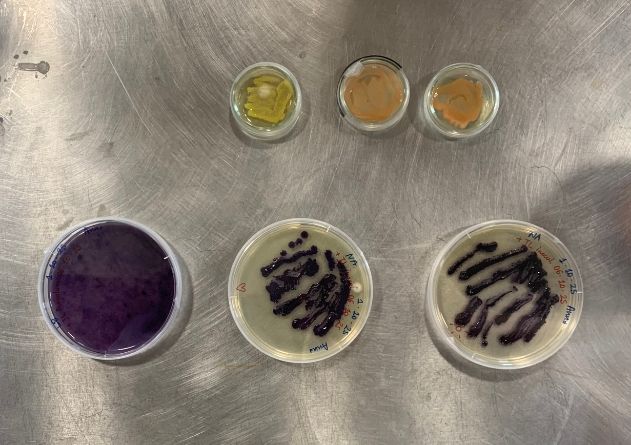

4. BIOCHROMES¶
INSPIRATION¶
- Mushroom Color Atlas - fascinating book and inspiring topic to dye with mushrooms
- Rebecca Desnos - has an inspiring instaram canal on dyeing fabrics
- Living Color - research on dyeing textiles with bacterial dyeing which I would love to know more about
- Botanical color - shares recipies for mordanting and dyeing on their website
- Ochre Archive - collects and preserves ochres from around the world to honor the significance of natural pigments.
NATURAL DYEING¶
The natural dyeing process typically consists of weighing the fibers or fabrics, cleaning, mordanting and dyeing.
Weighting & Cleaning¶
Weight the Fibers
Before starting any dyeing or mordanting process, the fibers must be weighed. All calculations for dyes and mordants are based on the weight of the dry fibers or fabrics. This weight measurement is known as the Weight Of Fiber (WOF). For example, we worked with 150 g of cotton and 100 g of wool. After weighing the fibers, we cut them into smaller pieces of approximately 10 g each to test a variety of shades.
Cleaning
The cotton has to be cleaned to remove any leftover substances from the manufacturing process. Even if a fabric is organic and not bleached, cleaning is necessary. If the fabric is not cleaned, the mordant and color will not attach well, which results in uneven coloration.
Cleaning Cotton
First, we placed the cotton pieces in tap water so they could absorb moisture evenly. This ensures they will later take in the soda solution uniformly. Working with yarns: Before we put yarn into a pot, we tied it up securely.
We then prepared a pot with water and sodium carbonate (also known as washing soda), heating it to a simmer. Cotton should be simmered at around 90 °C, while linen can also be processed at similarly high temperatures. After about an hour, we removed the cotton, rinsed it thoroughly in fresh water to remove the soda, and hung it up to dry slightly.
Cleaning Wool
Protein fibers usually also need to be cleaned for the same reasons. We skipped that part and only soaked the wool in warm water. Warm water is used to remove oxygen quicker. The wool must be soaked so that it is completely wet and can then absorb the dye better.
Mordanting¶
Fibers need to be mordanted to open their structure, allowing the color to adhere properly. Without mordanting, the dye will either not stick to the fibers at all, appear duller, or produce colors that are not colorfast and fade quickly. The mordanting process is different either having protein fibers ( wool & silk) or plant based fibers ( cotton & linen). Moreover, there are serveral ways to mordant. We choose to mordant cotton with Triacetat and Wool with Alum.
Mordanting Cotton with Triacetat¶
One liter of the mordant lasts for around 500–600 g WOF (weight of fiber). We can either buy triacetate as a mordant or prepare it ourselves. Since the second option is cheaper, we chose to prepare it ourselves. This mordant is suitable for cotton and linen but not for wool or silk.
Preparing the Triacetate solution
- 500 ml vinegar
- 50 g aluminium sulfate (usually used for gardening)
- 25 g sodium carbonate 99,7%
- Put 500 ml vinegar in a jar.
- Add 50 g aluminium sulfate.
- Mix with a hand blender.
- Add 25 g sodium carbonate slowly, step by step – it foams a lot.
- The solution should become transparent – keep going until it is not bubbling anymore and there are no crystals of sodium carbonate left. You may not need to add all of it; this depends on the acidity of the white vinegar, usually between 5–7 %.
Preparing the Solution for Neutralising the Triacetate
Prepare a 1 % solution by mixing the percarbonate and water – in our case 2 liter of water and 2 g percarbonate
- 2 g percarbonate ( important – not other carbonates like bicarbonate, because this is the most gentle one)
- 2 l water
If both solutions are prepared it mordanting process can start.
Mordanting Process
-
We had two jars: one with the triacetate and one with the percarbonate.
-
Put the fabric in the triacetate, squeeze it out, and hang to dry for around 1 hour. - it has to be completely dry.
-
Afterwards, use the percarbonate to neutralise the acidity of the triacetate. If you skip this, the fabric stays acidic and might change the colour of the dye bath. Percarbonate is a gentle way of neutralising the fabric.
-
Afterwards the fabric is ready for the dye bath
Mordanting Wool & Silk¶
Recipe:
- 15% Potassium Aluminum Sulfate (Alum)
- A pinch of cream of tartar powder (about a quarter teaspoon)
- Enough water for the fabric to move freely
-
Add 15% Potassium Aluminum Sulfate to a pot of water. The percentage refers to the weight of fiber (WOF) measured at the beginning—for example, for 100 g of wool, use 15 g of alum.
-
Add a pinch of cream of tartar powder to help the fibers stay shiny, which is especially important for silk.
-
Let the mixture simmer for 30 minutes to 1 hour, then allow it to cool in the pot before using.
Natural Dyes¶
Here is a list of dye plants we used this week. It is advisable to purchase from the same stores to ensure consistent quality.
| Dye | German Term | Botanical Term | Botanical Part | Colours Achieved | Amount of Dye (% of WOF) |
|---|---|---|---|---|---|
| Madder | Krappwurzel | Rubia tinctorum | Root | orange, orangey-reds, beige | 200% of WOF |
| Alkannet | Alkanna | Alkanna tinctoria | Root | Shades of purple | 150% |
| Chinese rhubarb | Chinesischer Rhabarber | Rheum tanguticum | Root | Yellow brown, green, coral | 150% |
| Weld | Färberwaid | Reseda luteola | Leaf, stem, flower | Bright lemon yellow, green when mixed with indigo | 150% |
| Safflower | Färberdistel | Carthamus tinctorius | Flower | Yellow and pink | 130% |
| African Marygold | Ringelblume | Tagetes erecta | Flower | strong yellows, green-yellows, golden-yellow | 150% |
| Hollyhock flower | Stockrose | Alcea rosea nigra | Flower | light blueish-greens | 150% |
| Coreopsis flower | Mädchenauge | Coreopsis tinctoria | Flower | Strong orange, brown | 75% |
| Black beans | Schwarze Bohne | Seed | grey,light blue | 400 g | |
| Logwood | Blauholz | Haematoxylum campechianum | Wood | Deep purples, blues, and blacks | 100% |
| Red onion peel | Rote Zwiebelschale | Peel | yellow, green | Some | |
| Indigo | Indigo | Indigofera tinctoria | Leaf | different shades of blue | 7 g/liter |
| Cochineal | Cochenille | Dactylopius coccus | Insect | shades of pink | ? |
Dyeing¶
Setting up dye bath¶
After mordanting—or meanwhile—we started setting up the dye baths. Some of them needed to be soaked overnight, like madder and weld; we covered them with water and let them sit. For the other dye batches, we set up pots with water and added the calculated amount of dye.
We calculated the amount of dye based on the weight of fiber (WOF). For example, for madder, we used 200% of the WOF. We wanted to dye around 30 g of fabric, so we used 60 g of madder. The chart shows the amounts we worked with and includes comments on any special considerations.
To set up the dye bath, we filled a pot with water and heated it to about 80 degrees Celsius, always use stainless steal pots to avoid unwanted chemical reactions. We let the fabrics dye for at least half an hour. Good results are achieved by dyeing for about one hour or sometimes letting them sit overnight. After dyeing, the fabrics can be removed and rinsed with clean water.
Iron | Copper | Changing PH- value | Overdyeing¶
We tried several variations:
- Iron: Adding iron to a dye bath changes the color, so we added a small amount of iron (a knife-tip’s worth) and continued dyeing. Be careful that nothing touching the iron contacts other dye baths, because even a small crystal can change the color—use separate tools exclusively for iron.
- Copper: Same precautions and effects as iron.
- Overdyeing: It is also possible to overdye fabrics and create interesting shades. For example, dyeing fabric with weld to yellow, then putting it in an indigo bath, produces a nice blue-green shade.
- PH adjustments: Since some dyes are pH reactive, we added either citric acid or soda ash to achieve different shades.
Color Samples¶
These are the results of testing certain dyes on different fabric types. I used a collection of small fabric squares from a previous dyeing project to test various materials and see how the colors turn out. The fabrics included coarse wool fabric, fine wool fabric, pongee silk, thin cotton, linen, sturdy cotton twill, and cotton fabric and wool fibers sourced from the lab.
Here you find the color samples of our groupwork at Waag Textile Lab.
Hot Dyeing Process
Madder¶
Madder needs to be soaked overnight and should not be heated above 50 degrees Celsius, as higher temperatures disturb the dyeing pigments. (There is another kind of madder that can be heated.) The madder dye bath must be set up at a low temperature. Since madder releases a lot of dye, the madder pieces are left to swim in the pot during the entire dyeing process. To prevent the wool from getting dirty with all the tiny pieces of madder, it is placed in a silk bag which is then put back into the dye bath. Madder produces a beautiful red-orange color. Leaving the wool in the dye bath overnight intensifies the color. Adding iron produces shades of beige.
Alkanette¶
Alkanet must be dissolved in 99% ethanol. We used 150% weight of fiber (WOF) of alkanet and added 400 ml ethanol. It produces a light shade of purple. The pigment tends to separate from the ethanol.
Chinese Rhubarb¶
Chinese rhubarb must be soaked overnight. It gives yellowish-beige colors. With iron, it gives salmon shades; with iron and soaking overnight, it yields dark beige.
Weld¶
Weld gives a nice bright yellow color. It also needs to be soaked. It can be used to overdye with other colors like indigo, which produces nice shades of green. Weld can stay in the water a long time to release all its color—though not too long, as it develops a smell like vomit. Add chalk if the color is not bright enough.
Marygold¶
Marigold produces bright orange-yellow shades. Adding iron changes the color to gold. Adding iron and letting it sit overnight shifts the color to a dark turquoise green. It is an easy dye and always works; the dyeing is done directly in the pot.
Hollyhock¶
Hollyhock produces really beautiful, subtle green-blue colors. Adding soda creates pastel light green shades. Dyeing is done directly in the pot.
Coreopsis¶
Coreopsis produces orange shades. Adding iron results in light or strong brown tones. There are different types of coreopsis, some with more dye than others. We combined Coreopsis tinctoria and grandiflora.
Logwood¶
Logwood can produce a variety of colors. It contains purple and pink pigments. Only logwood produces a strong purple. Logwood is pH reactive; adding citric acid shifts the color to beige and yellowish tones. Combining weld and logwood produces a nice shade of green. Adding iron results in a dark blue, and adding copper yields a black. Copper or iron additions help the logwood color last longer without fading.
Red Onion Peels¶
Red onion peels produce brown colors. Adding soda gives a beautiful greenish shade. It’s nice to use kitchen waste for dyeing.
Cochineal¶
Cochineal produces strong pinks. Adding citric acid makes the color even brighter.
Cold Dyeing Processes
Safflower¶
Safflower requires a cold dyeing process. It contains yellow and red pigments. To get the pink pigments, the yellow pigments must first be removed by wetting the flowers repeatedly until the water runs clear (this is called laking). After laking, the flowers are soaked again in water and then put in water with 4% soda to raise pH to 11, then neutralized with vinegar to pH 7. The dye bath then yields pink color. Letting cotton soak overnight in the bath develops the pink color.
Black Beans¶
Black beans are dried, then soaked in water for a day. It is a cold dye that will fade eventually. The fabric is repeatedly put in and taken out for oxidation until the desired shade of gray or bluish is reached.
INDIGO¶
### Dyeing Process
- Measure the indigo powder and water. For example, 10.5 g of powder in 1.5 liters of water. Usually, 7 g per liter produces strong blue, while 5 g per liter gives lighter shades.
- Prepare the indigo paste:
- Put the measured powder into a mortar.
- Add a little hot water and stir to wet all pigments fully.
- Stir continuously until the paste is smooth and no particles remain (about 10 minutes).
- Prepare the dye vat chemicals:
- Use the ratio 1 part indigo : 2 parts calcium hydroxide (Löschkalk) : 3 parts fructose.
- For 10.5 g indigo, add 21 g calcium hydroxide and 31 g fructose.
- Dissolve calcium hydroxide slowly in cold water; do the same separately for fructose.
- Heat 1.5 liters of water in a pot.
- Add chemicals in order: indigo paste first, then fructose, then calcium hydroxide.
- Stir rapidly for 5 minutes with a flat tool near the edges to avoid introducing air while releasing bubbles.
- Look for the “indigo flower”—3-4 bubbles in the pot’s center with a coppery shine.
- Let the mixture settle until the liquid above is clear.
- Keep the vat warm on a water bath or heating mat.
- Remove any foam from the surface before dyeing.
- Dyeing the fabric:
- Dip the fabric straight down to avoid air entering the vat and to guarantee even dyeing.
- Keep the fabric submerged briefly, then remove and rinse immediately.
- Oxidation:
- The fabric will appear green initially; as it oxidizes in air, it will turn blue.
- Repeat dipping, rinsing, and oxidizing steps until the desired shade is achieved.
LAKING PIGMENTS¶
- Lake pigments can be dissolved in alkalies or ethanol.
- Lake pigments are especially suitable for dyeing protein fibers.
- Setting up a dye bath with laked pigments it helps to produce more even and reproducible color tones.
- Most pigments used in laking have a pH around 6–7, but some, like those from onions and chalk, require a pH of 8–9.
- Mordant dyes work well for laking processes.
Laking Process¶
For laking pigments we used Safflower - we did two different kind of laking processes one with alum & soda and one with alum & chalk
Preparing Safflower
- Safflower contains pigments for both yellow and pink colors. The yellow dye is short-lived and mostly considered a leftover, while achieving pink takes 1–2 days due to waiting times.
- Use 40 g of safflower petals soaked in 2 liters of water for 2 hours.
- Strain and wash the petals repeatedly until the water runs clear—this prepares the bath for pink dye extraction.
- For leftover dye baths with little color, use 10 g alum per liter; for strong fresh batches, use more alum.
- Alum is the base for pigment formation. Stronger pigments come from using a sufficient amount of alum. It is better to have fewer but stronger pigments than many weak ones. The amount of water used does not matter.
Laking Process with alum & soda
- Filter the soaked safflower petals through a sieve, then squeeze the petals.
- Filter again through a cloth for finer filtration.
- Use a large vessel because of frothing.
- Prepare two solutions: 2 parts alum : 1 part sodium carbonate
- Solution: 25 g alum (or half for less concentrated baths we used 10g for leftover dye bathes), dissolved in hot water with stirring.
- Solution: 12.5 g sodium carbonate, dissolved in water (quantity does not matter), stirring as well.
- Add the alum solution to the dye bath and stir.
- Add soda ash slowly, little by little, to avoid excessive reactions caused by pH differences. Stir intermittently and add more until reaction settles.
- Pigments will start to separate from the liquid, creating a matte color suitable for screen printing or pastels.
Laking process with alum & chalk
- Instead of soda, use the same amount of alum and 12.5 g of chalk. → 2 parts alum : 1 part chalk
- Add alum solution to the dye bath, stir well.
- Add chalk to the dye bath, stirring continuously.
- Stir briskly using a whisk held between the hands, moving quickly side to side.
After Laking
Two options after laking pigments:
-
Filter immediately using a large fine filter (like circular round coffee filters or Japanese coffee filters, which filter finely and don’t break easily).
-
Wait for the pigments to settle; sediment will form at the bottom and clear liquid on top. Dry the pigment quickly afterward.
Dry pigments at the air, dehydrator , heat matt or on a gypsum plate to absorb excess liquid.
Washing Pigments
-
Wash the pigments if necessary. Washing helps remove residual carbonate and is mostly needed if you suspect carbonate remains (visible as white spots on dried pigment).
-
The leftover water should be near neutral pH (~7), basically just water - then no washing needed
Processing Strained Pigments
- Pigments can be used for watercolor or soft pastel.
- Use a grinder (such as an old coffee grinder) to grind pigments finely (do not inhale pigment dust).
- To dissolve pigments for dyeing wool or silk, vinegar is used. Vinegar works well on wool and silk but not on cotton.
BACTERIA DYEING¶
Bacteria for dyeing¶
Janthinobacterium lividum – produces purple pigment
Serratia marcescens – produces pink, red, and yellow pigments
There are more bacterias to dye with but we will only use these as they are safety level one.
Preparing Fabric¶
Befor going to the biolab we had to prepare our fabrics. We used a piece of silk, folded it using the shibori technique to achieve patterned effects similar to bundle dyeing or batik. The folded fabric should fit inside a 9 cm diameter Petri dish and not touch the lit for better bacteria growing.
Janthinobacterium lividum¶
- Growth period: approximately 1 week.
- Purple pigment comes from the substance violacein found in J. lividum, a bacterium found on frog skin.
- Pigment is UV-active – cultures should not be grown in complete darkness, as pigment production will fail.
- Optimal growing temperature: 24–28 °C. Temperatures above 30 °C allow bacteria to grow but prevent visible pigment production.
Growing medium¶
Bacterial dyeing can be set up either on:
- Petri dishes with solid medium such as nutrient agar standard one.
- Petri dishes with liquid medium such as Luria Broth (LB).
Liquid medium is suitable for growing bacteria directly on the surface of the fabric.
LB broth and nutrient agar are pH‑neutral.
Serratia marcescens – pigment is pH‑sensitive; increasing acidity in the medium leads to a stronger red color.
Liquid Medium for J. lividum¶
For 1 liter you use usually 25 of Lruia broth. We worked with:
- 400 ml distilled water
- 10 g Luria Broth powder
- A few drops of glycerin (J. lividum prefers sweet medium; S. marcescens does not)
Mix all ingredients in a lab bottle and shake until well dissolved.
Autoclaving¶
Autoclaving Growing Medium and Fabric
Normally, fabric is autoclaved in an autoclave bag, but with small samples we autoclaved them directly in a Petri dish.
Place Petri dishes in the autoclave along with the bottles of liquid medium.
Always open bottle lids slightly so steam can escape, otherwise bottles may explode.
After autoclaving and before removing bottles, close the lids immediately to maintain sterility.
Autoclave Steps
There is an instruction next to the autoclave in the lab but still here are the main steps.
- Water level must be 3.5 L before starting (indicator light blinks if too low).
- Fit the hose into the round opening when closing the lid.
- Tighten all screws gradually and evenly, then firmly.
- Open the top vent before starting.
- Start the autoclave. When temperature reaches ~100 °C and the unit beeps, close the vent to build pressure (caution: hot).
- Heat to 121 °C for 20 minutes (unit beeps when at temperature).
- Allow to cool automatically.
- At ~85 °C, open the vent to release steam. Never open the lid while under pressure.
- After pressure release, open carefully – contents will still be hot.
- Close bottle lids while inside, then remove items carefully.
- Cool the broth before use, otherwise bacteria will die.
Sterile Workspace¶
- Place a gas burner on the table.
- Spray ethanol around the burner to sterilize the area, keeping it wet.
- Disinfect hands frequently.
- Open Petri dish lids and bottle caps only as much as necessary, work quickly.
- Avoid breathing over the sterile area.
- Place ethanol bottles away from the gas flame for safety.
Inoculating a petri dish with bacteria¶
We will basically take bacteria from an existing culture and streak them onto a fresh plate.
- Liquefy solid nutrient agar in the microwave if needed, then pour into a sterile Petri dish under sterile environment
- As only a small amount of agar is used, it solidifies and cooles down quickly.
- Sterilize the inoculation stick in the flame until red-hot.
- Open the lid of the petridish with the bacteria, cool the stick briefly on the sterile agar on a spot where there is no bacteria, then pick up some of the bacteria on the stick. Our culture had a glue-like blue substance due to age.
- Close the lid and open the lid of the other petri dish
- Spread bacteria across the new agar plate in cross patterns.
- Seal the plate with parafilm tape - a tape with seals the petridish. Letting air but but nothing in
Note: having a shaking incubator helps to let the bacteria grow even
Inoculating Fabric¶
Similar procedure as before.
- Work in an sterile enviornment with gas burner and ethanol
- Pour LB broth into the autoclaved Petri dish with fabric. Close the lid.
- Sterilize the inoculation stick with the gas burner, cool it on the agar and transfer bacteria from an agar plate into the broth covering the fabric.
- The broth should be put all over the farbic but it should not totally be covered by it.
- Seal and label the dish.
- Incubate for ~1 week in the incubator.
Afterwards
- Autoclave any bottles, media, and equipment no longer needed.
- Clean and disinfect the lab area.
- Disinfect and wash hands.